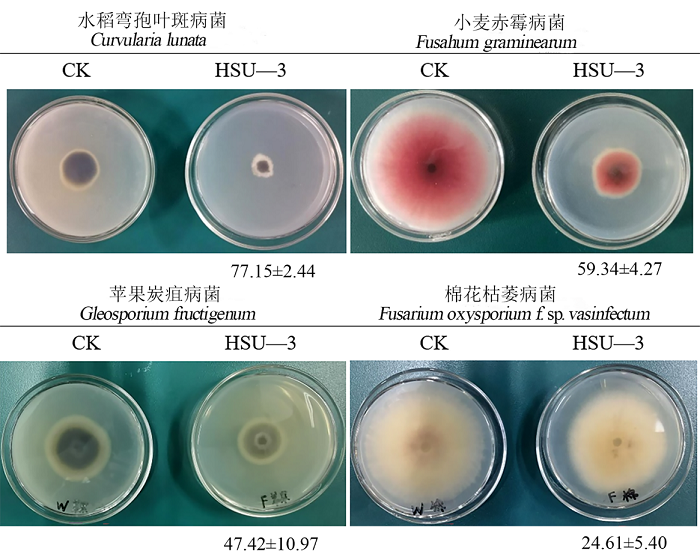

时间:2024-06-11 浏览:780
2024年6月6日,休宁县召开2024年度绿色食品产业科技特派团成果转化暨科技特派员助力乡村振兴培训会;我院柏晓辉教授受邀在培训会上做农作物病害防治技术推介。柏晓辉以其课题组筛选自祁白术中的一株贝莱斯芽孢杆菌在防治水稻弯孢叶斑病上的应用为案例,向大家介绍生物防治在现代农业种植中的应用潜力、前景及趋势。其后,柏晓辉又以其团队在歙县山核桃根腐病防治中的成功经验为案例,向大家推介农作物种植中的生态治理模式,介绍其关键技术和注意事项等;报告受到与会人员一致好评。

(撰稿/摄影:生物技术教研室;审核:太阳成集团tyc7111 潘健)
版权所有 ©️ 中国·tyc7111cc太阳成(VIP认证集团)官方网站-Suncity Club
办公电话:(0559) 2546613 办公邮箱:SHYXZ#mail.hsu.edu.cn(请将#替换为@)
地址:安徽省黄山市屯溪区西海路39号(率水校区)